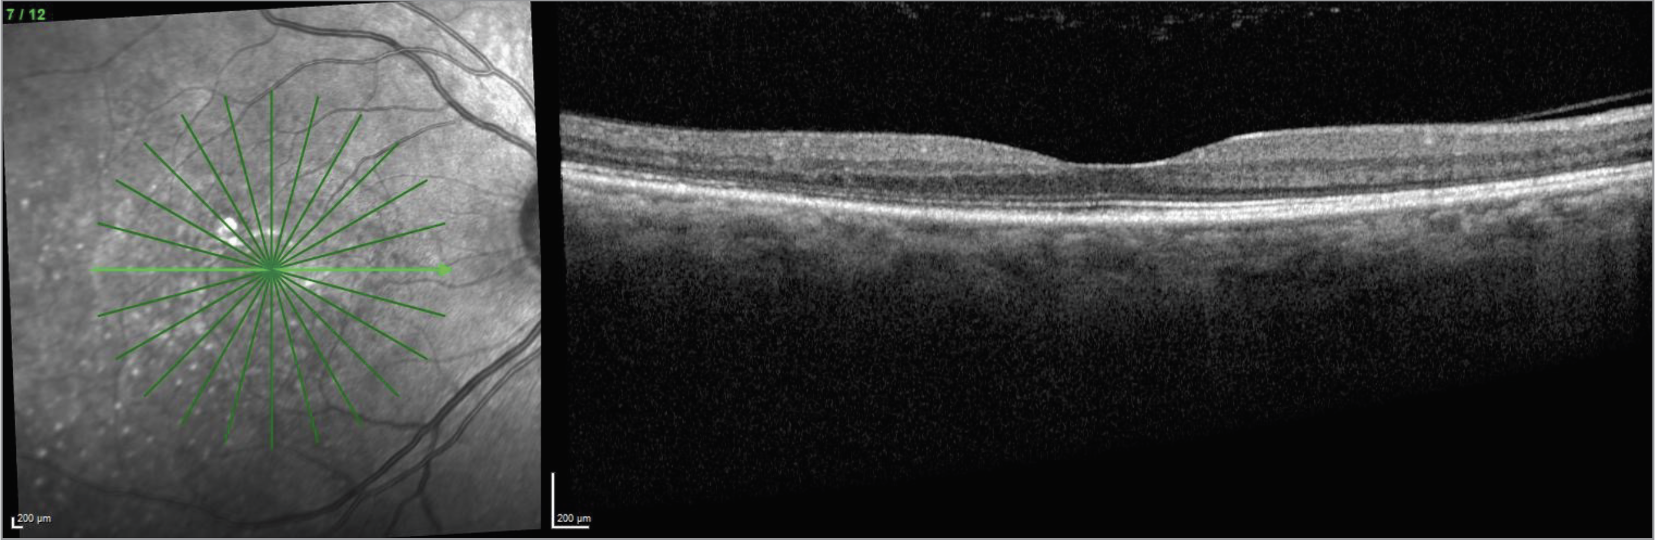
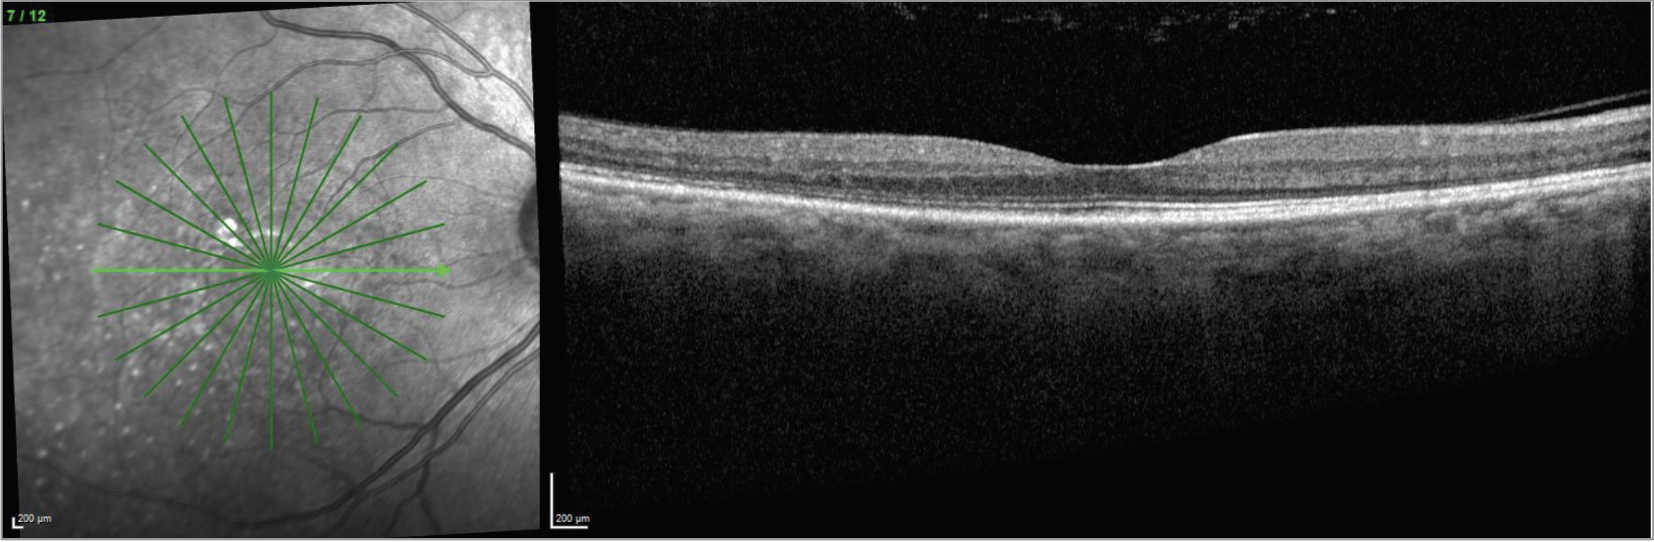
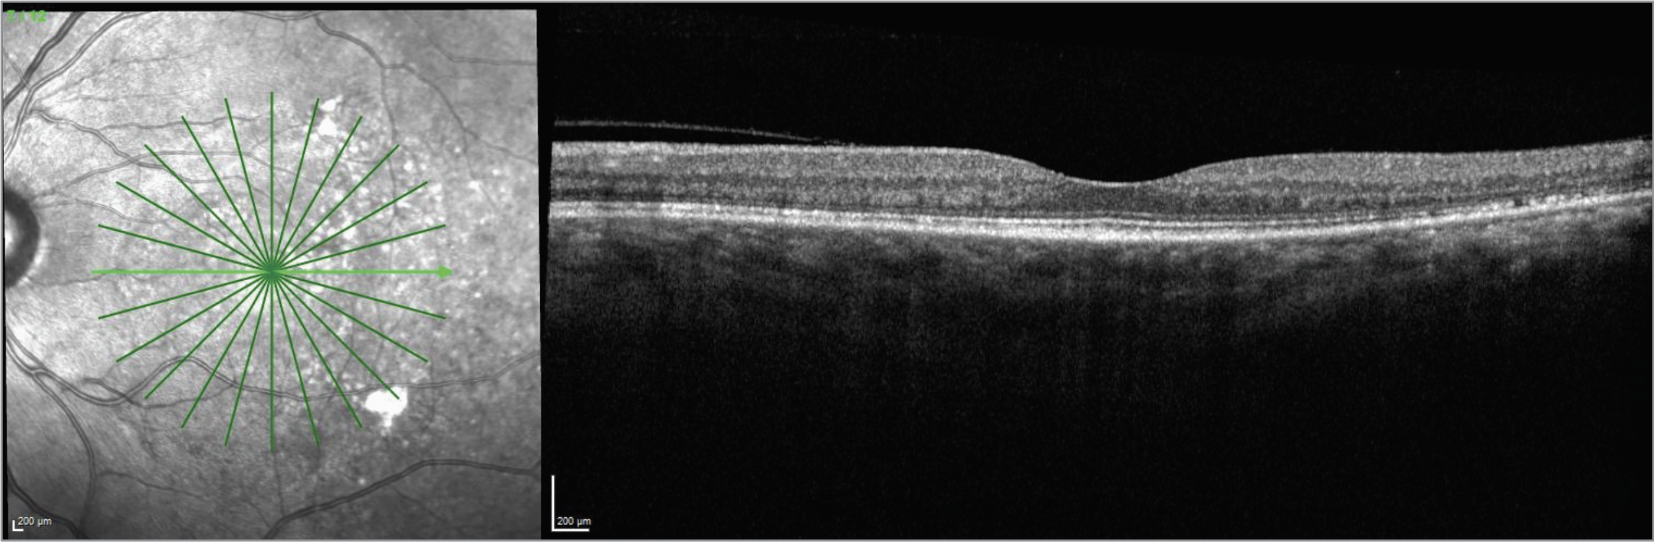

|
|
Bios Erik Massenzio, MD, is a retina fellow at Wills Eye Hospital. |
A 45-year-old Black female with no past medical or ocular history presented with blurry vision in both eyes after one week of severe headache. Snellen visual acuity was counting fingers in both eyes. Intraocular pressures were normal in both eyes. Anterior segment examination was normal and there were 1+ cells in the anterior vitreous of both eyes.
 |
| Figure 1. Pseudo color fundus photo of the right eye with 360 degrees of serous choroidal detachments, bacillary detachments, and exudative subretinal fluid. |
Fundoscopic examination of both eyes demonstrated normal optic discs and normal vasculature; however, there were 360 degrees of serous choroidal detachments and large pockets of subretinal fluid throughout the macula and mid-periphery (Figures 1, 2). Fundus autofluorescence demonstrated hyperautofluorescence within the pockets of subretinal fluid in the macula and mid-periphery of both eyes (Figure 3). Fluorescein angiography revealed diffuse leakage of the peripheral vessels in both eyes and pooling corresponding to the pockets of subretinal fluid in both eyes. There were pinpoint areas of hyperfluorescence, most notable in the left eye, reminiscent of a “starry sky” appearance (Figure 4). Indocyanine green angiography revealed mixed hyper- and hypofluorescence of the macula. Optical coherence tomography of both eyes demonstrated multiple areas of large bacillary detachments in both eyes (Figures 5, 6).
 |
| Figure 2. Pseudo color fundus photo of the left eye with 360 degrees of serous choroidal detachments, bacillary detachments and exudative subretinal fluid. |
Our differential diagnosis for this patient included Vogt-Koyanagi-Harada disease, bilateral posterior scleritis, sarcoidosis, lymphoma, uveal effusion syndrome, malignant hypertension, syphilis and tuberculosis. A broad laboratory workup for these infectious and inflammatory etiologies was ultimately negative. The diagnosis of VKH disease was made based on the patient’s clinical presentation and imaging findings.
The patient was started on topical difluprednate four times daily in both eyes, atropine twice daily in both eyes and oral prednisone dosed at 1 mg/kg per day. After two weeks, the bacillary detachments were noted to have worsened, and the patient’s vision subjectively declined further to hand motions in both eyes. At this time, the decision was made to admit the patient for pulse-dose steroids with initiation of infliximab. The patient completed five days of IV methylprednisolone 250 mg administered every six hours. Rheumatology was consulted to initiate infliximab.
 |
| Figure 3. Fundus autofluorescence of the right eye demonstrating hyper autofluorescence corresponding to pockets of subretinal fluid and bacillary detachments, degrees of serous choroidal detachments, bacillary detachments and exudative subretinal fluid. |
One week after pulse-dose steroids and starting infliximab, the bacillary detachments had completely resolved in both eyes, with improvement of visual acuity to 20/80 in the right eye and 20/70 in the left eye.
The patient was continued on infliximab dosed at 5 mg/kg every eight weeks, and oral prednisone was decreased by 5 mg per week.
After one month of being off prednisone, her serous choroidal detachments and bacillary detachments recurred. The patient was restarted on 40 mg daily of prednisone, and her infliximab was increased to 7.5 mg/kg. After tapering the prednisone following this flare, she was continued on infliximab at 7.5 mg/kg for an additional one and a half years.
The patient has now remained stable for one year after stopping infliximab, and her visual acuity has improved to 20/20 in both eyes.
 |
| Figure 4. Fluorescein angiogram of the left eye revealing diffuse leakage of peripheral vessels and “starry sky” appearance of the temporal midperiphery. |
Discussion
VKH disease is a rare autoimmune disorder characterized by anterior and posterior uveitis, vitiligo, headache and hearing loss.1 Classically, VKH is divided into four stages: First, the prodromal stage, which typically includes fevers, headaches and neck pain. Second, the uveitic stage, featuring anterior or posterior uveitis including classic features such as choroidal detachments with subretinal fluid and bacillary detachments with a starry sky appearance on fluorescein angiogram, many of which were seen in our case. Third, the chronic stage describes the development of vitiligo, depigmentation of the choroid and poliosis. Fourth, the recurrent stage describes acute recurrences of uveitis, most commonly anterior uveitis.
 |
| Figure 5. OCT of the right eye demonstrating a massive bacillary detachment. |
Treatment of VKH involves steroids and immunomodulatory therapy. Numerous studies recently have advocated for early treatment with immunomodulatory therapy in order to improve the relentless course of this inflammatory disease.1-3 In one study, when immunomodulatory therapy was initiated within six weeks of presentation, patients had a better visual outcome at four years that was statistically significant.4 As for choice of immunomodulatory therapy, anti-TNF agents have become popular; however, other agents including azathioprine, cyclosporine and mycophenolate have also been used.5
|
| Figure 6. OCT of the left eye revealing mixed subretinal fluid and bacillary detachments. |
In this case, the presence of a bacillary detachment was critical for making the diagnosis of VKH in a timely manner. “Bacillary” means “shaped like a rod”; a bacillary layer detachment is named as such because photoreceptors are approximately rod-shaped, and the detachment involves splitting of the photoreceptors at the level of the inner segment myoid. It can be recognized on OCT as fluid between the ellipsoid zone and the external limiting membrane.
|
| CaptionFigure 7. OCT of the right eye one year after stopping infliximab. |
In terms of mechanism, one hypothesis is that a bacillary layer detachment occurs when the accumulation of subretinal fibrin modulates the adhesion between the photoreceptor outer segments and the apical microvilli of the retinal pigment epithelium.6 Subretinal exudation then exerts hydrostatic pressure, leading to the bacillary layer detachment.
In a literature review of cases of bacillary detachments, most reported cases of bacillary layer detachments were seen in VKH and other inflammatory diseases.6
|
| Figure 8. OCT of the left eye one year after stopping infliximab. |
The Bottom line
When VKH syndrome is suspected, prompt treatment with steroids and immunomodulatory agents is important. Presence of bacillary layer detachment can lead to higher suspicion of VKH syndrome, especially in the right clinical context, although it can also be found in other inflammatory diseases. With prompt and effective treatment, patients can achieve remarkable restoration of their vision. RS
Reference
1. Lavezzo MM, Sakata VM, Rodriguez EEC, et al. Subclinical signs persistence in Vogt-Koyanagi-Harada disease (VKHD) patients treated with early high-dose corticosteroids and immunosuppressive therapy (IMT). Investigative Ophthalmology & Visual Science 2018;59:9:422-422.
2. Urzua CA, Velasquez V, Sabat P, et al. Earlier immunomodulatory treatment is associated with better visual outcomes in a subset of patients with Vogt-Koyanagi-Harada disease. Acta ophthalmologica 2015;93:6:e475-e480.
3.Paredes I, Ahmed M, Foster CS. Immunomodulatory therapy for Vogt-Koyanagi-Harada patients as first-line therapy. Ocular immunology and inflammation 2006;14:87-90.
4. Oo EEL, Chee SP, Wong KKY, et al. Vogt-Koyanagi-Harada disease managed with immunomodulatory therapy within 3 months of disease onset. American Journal of Ophthalmology 2020;220:37-44.
5.Rahman N, Artiaga JC, Bouras K, et al. Immunosuppressive therapy for Vogt-Koyanagi-Harada disease: A retrospective study and review of literature. Journal of Ophthalmic Inflammation and Infection 2023;13:1:27.
6. Ramtohul P, et al. Bacillary layer detachment: Multimodal imaging and histologic evidence of a novel optical coherence tomography terminology: Literature review and proposed theory. Retina 2021;41:11:2193-2207.



